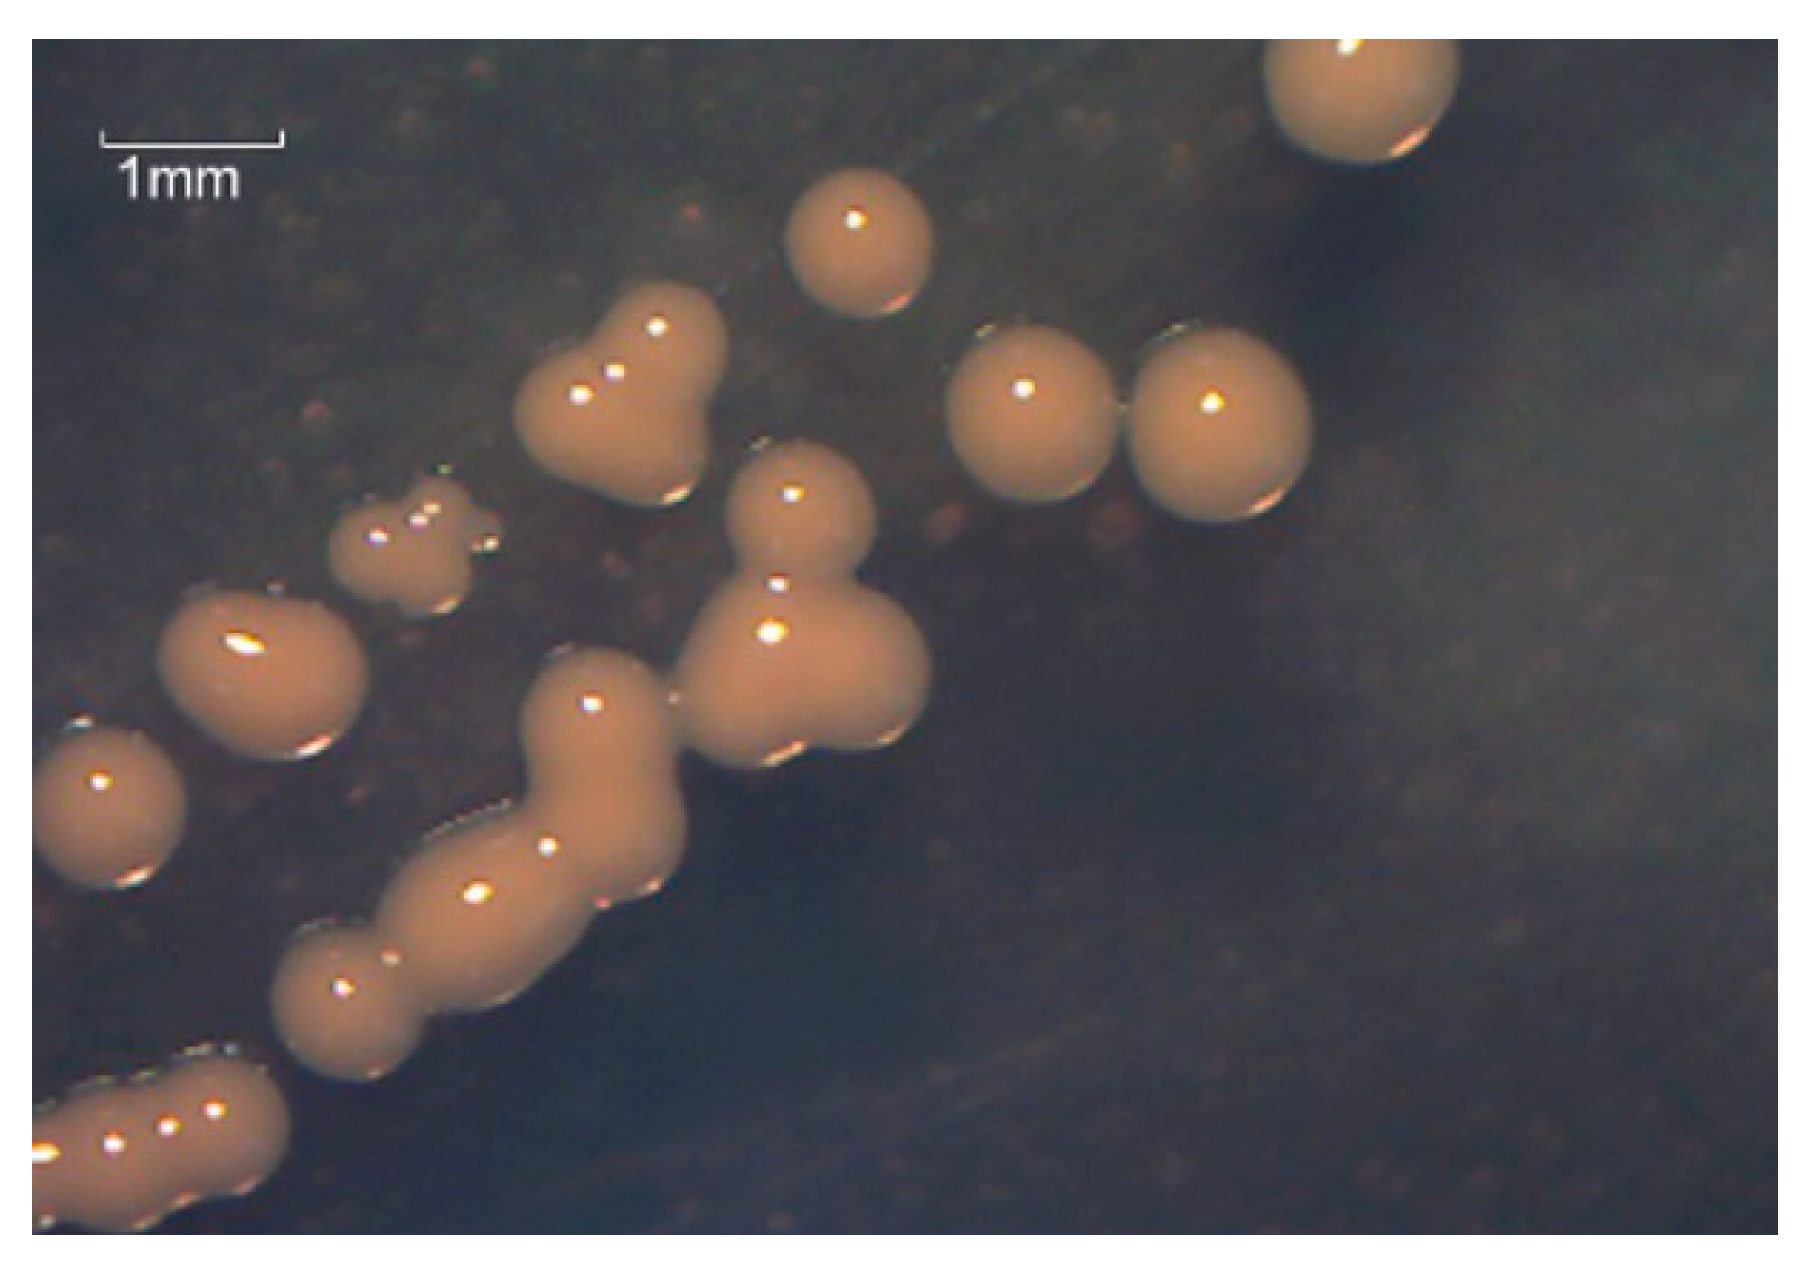
Microorganisms 10 01441 g001 Microorganisms 10 01441 g001

Aerobic Degradation Characteristics of Decabromodiphenyl ether through Rhodococcus ruber TAW-CT127 and Its Preliminary Genome Analysis
Abstract
1. Introduction
2. Materials and Methods
2.1. Chemicals and Media
2.2. Isolation of Strain TAW-CT127
2.3. Identification of Strain TAW-CT127
2.4. Morphological Observation and Physiological and Biochemical Characteristics of the Strain
2.5. Optimal Growth Conditions for Strain TAW-CT127
2.6. Observation of the Surface Morphology of TAW-CT127 under Different Culture Conditions
2.7. Degradation Characteristics of BDE-209 by Strain TAW-CT127
2.7.1. Degradation Rate of BDE-209 by TAW-CT127
2.7.2. Detection of BDE-209 Metabolites
2.8. Genomic Sequencing and Analysis of TAW-CT127
2.8.1. DNA Extraction, Library Construction, and Genome Sequencing
2.8.2. Genome Assembly and Functional Annotation
2.9. Statistical Analysis
3. Results and Discussion
3.1. Morphological Observation, Physiological and Biochemical Characteristics, and Optimum Growth Conditions of the Strain
3.2. Molecular Biological Identification
3.3. Study on the Degradation Characteristics of BDE-209 by Strains
3.3.1. Observation of Strains Growing in Different Culture Media
3.3.2. Degradation Characteristics of BDE-209 by Strain TAW-CT127
3.4. Genome Information of Strain TAW-CT127
3.4.1. Genomic Properties of Strain TAW- CT127
3.4.2. COG Database Annotation
3.4.3. KEGG Database Annotation
3.4.4. Analysis of BDE-209 Degradation-Related Genes
4. Conclusions
Supplementary Materials
Author Contributions
Funding
Institutional Review Board Statement
Informed Consent Statement
Acknowledgments
Conflicts of Interest
References
- Naert, C.; Van Peteghem, C.; Kupper, J.; Jenni, L.; Naegeli, H. Distribution of Polychlorinated Biphenyls and Polybrominated Diphenyl Ethers in Birds of Prey from Switzerland. Chemosphere 2007, 68, 977–987. [Google Scholar] [CrossRef] [PubMed]
- Chen, Y.; Li, J.; Tan, Q. Trends of Production, Consumption and Environmental Emissions of Decabromodiphenyl Ether in Mainland China. Environ. Pollut. 2020, 260, 114022. [Google Scholar] [CrossRef] [PubMed]
- Xiong, J.; Li, G.; An, T.; Zhang, C.; Wei, C. Emission Patterns and Risk Assessment of Polybrominated Diphenyl Ethers and Bromophenols in Water and Sediments from the Beijiang River, South China. Environ. Pollut. 2016, 219, 596–603. [Google Scholar] [CrossRef] [PubMed]
- Xu, J.; Qian, W.; Li, J.; Zhang, X.; He, J.; Kong, D. Polybrominated Diphenyl Ethers (PBDEs) in Soil and Dust from Plastic Production and Surrounding Areas in Eastern of China. Environ. Geochem. Health 2019, 41, 2315–2327. [Google Scholar] [CrossRef]
- Akortia, E.; Olukunle, O.I.; Daso, A.P.; Okonkwo, J.O. Soil Concentrations of Polybrominated Diphenyl Ethers and Trace Metals from an Electronic Waste Dump Site in the Greater Accra Region, Ghana: Implications for Human Exposure. Ecotoxicol. Environ. Saf. 2017, 137, 247–255. [Google Scholar] [CrossRef]
- Chen, D.; Bi, X.; Zhao, J.; Chen, L.; Tan, J.; Mai, B.; Sheng, G.; Fu, J.; Wong, M. Pollution Characterization and Diurnal Variation of PBDEs in the Atmosphere of an E-Waste Dismantling Region. Environ. Pollut. 2009, 157, 1051–1057. [Google Scholar] [CrossRef]
- Lee, R.G.M.; Thomas, G.O.; Jones, K.C. PBDEs in the Atmosphere of Three Locations in Western Europe. Environ. Sci. Technol. 2004, 38, 699–706. [Google Scholar] [CrossRef]
- Qiu, X.; Zhu, T.; Hu, J. Polybrominated Diphenyl Ethers (PBDEs) and Other Flame Retardants in the Atmosphere and Water from Taihu Lake, East China. Chemosphere 2010, 80, 1207–1212. [Google Scholar] [CrossRef]
- Chen, D.; Hale, R.C. A Global Review of Polybrominated Diphenyl Ether Flame Retardant Contamination in Birds. Environ. Int. 2010, 36, 800–811. [Google Scholar] [CrossRef]
- Chen, L.; Wang, X.; Zhang, X.; Lam, P.K.S.; Guo, Y.; Lam, J.C.W.; Zhou, B. Transgenerational Endocrine Disruption and Neurotoxicity in Zebrafish Larvae after Parental Exposure to Binary Mixtures of Decabromodiphenyl Ether (BDE-209) and Lead. Environ. Pollut. 2017, 230, 96–106. [Google Scholar] [CrossRef]
- Wang, Y.; Zhang, H.; Cao, J. Exploring the Interactions of Decabrominateddiphenyl Ether and Tetrabromobisphenol A with Human Serum Albumin. Environ. Toxicol. Pharm. 2014, 38, 595–606. [Google Scholar] [CrossRef] [PubMed]
- Wu, Z.; He, C.; Han, W.; Song, J.; Li, H.; Zhang, Y.; Jing, X.; Wu, W. Exposure Pathways, Levels and Toxicity of Polybrominated Diphenyl Ethers in Humans: A Review. Environ. Res. 2020, 187, 109531. [Google Scholar] [CrossRef] [PubMed]
- de Wit, C.A. An Overview of Brominated Flame Retardants in the Environment. Chemosphere 2002, 46, 583–624. [Google Scholar] [CrossRef]
- Noyes, P.D.; Lema, S.C.; Macaulay, L.J.; Douglas, N.K.; Stapleton, H.M. Low Level Exposure to the Flame Retardant BDE-209 Reduces Thyroid Hormone Levels and Disrupts Thyroid Signaling in Fathead Minnows. Environ. Sci. Technol. 2013, 47, 10012–10021. [Google Scholar] [CrossRef]
- Xie, X.; Qian, Y.; Wu, Y.; Yin, J.; Zhai, J. Effects of Decabromodiphenyl Ether (BDE-209) on the Avoidance Response, Survival, Growth and Reproduction of Earthworms (Eisenia Fetida). Ecotoxicol. Environ. Saf. 2013, 90, 21–27. [Google Scholar] [CrossRef]
- Ni, K.; Lu, Y.; Wang, T.; Shi, Y.; Kannan, K.; Xu, L.; Li, Q.; Liu, S. Polybrominated Diphenyl Ethers (PBDEs) in China: Policies and Recommendations for Sound Management of Plastics from Electronic Wastes. J. Environ. Manag. 2013, 115, 114–123. [Google Scholar] [CrossRef]
- Li, X.; Liu, J.; Zhou, G.; Sang, Y.; Zhang, Y.; Jing, L.; Shi, Z.; Zhou, X.; Sun, Z. BDE-209 and DBDPE Induce Male Reproductive Toxicity through Telomere-Related Cell Senescence and Apoptosis in SD Rat. Environ. Int. 2021, 146, 106307. [Google Scholar] [CrossRef]
- Shaoyong, W.; Zhang, W.; Wang, C.; Kou, Z.; Pang, W. BDE-209 Caused Gut Toxicity through Modulating the Intestinal Barrier, Oxidative Stress, Autophagy, Inflammation, and Apoptosis in Mice. Sci. Total Environ. 2021, 776, 146018. [Google Scholar] [CrossRef]
- Zhang, Y.; Luo, X.; Mo, L.; Wu, J.; Mai, B.; Peng, Y. Bioaccumulation and Translocation of Polyhalogenated Compounds in Rice (Oryza Sativa L.) Planted in Paddy Soil Collected from an Electronic Waste Recycling Site, South China. Chemosphere 2015, 137, 25–32. [Google Scholar] [CrossRef]
- Chen, T.; Niu, P.; Kong, F.; Wang, Y.; Bai, Y.; Yu, D.; Jia, J.; Yang, L.; Fu, Z.; Li, R.; et al. Disruption of Thyroid Hormone Levels by Decabrominated Diphenyl Ethers (BDE-209) in Occupational Workers from a Deca-BDE Manufacturing Plant. Environ. Int. 2018, 120, 505–515. [Google Scholar] [CrossRef]
- Li, X.; Zhang, Y.; Dong, X.; Zhou, G.; Sang, Y.; Gao, L.; Zhou, X.; Sun, Z. DNA Methylation Changes Induced by BDE-209 Are Related to DNA Damage Response and Germ Cell Development in GC-2spd. J. Environ. Sci. 2021, 109, 161–170. [Google Scholar] [CrossRef] [PubMed]
- Sun, Y.; Wang, Y.; Liang, B.; Chen, T.; Zheng, D.; Zhao, X.; Jing, L.; Zhou, X.; Sun, Z.; Shi, Z. Hepatotoxicity of Decabromodiphenyl Ethane (DBDPE) and Decabromodiphenyl Ether (BDE-209) in 28-Day Exposed Sprague-Dawley Rats. Sci. Total Environ. 2020, 705, 135783. [Google Scholar] [CrossRef] [PubMed]
- Sun, S.; Jin, Y.; Yang, J.; Zhao, Z.; Rao, Q. Nephrotoxicity and Possible Mechanisms of Decabrominated Diphenyl Ethers (BDE-209) Exposure to Kidney in Broilers. Ecotoxicol. Environ. Saf. 2021, 208, 111638. [Google Scholar] [CrossRef] [PubMed]
- Zezza, D.; Tait, S.; Della Salda, L.; Amorena, M.; Merola, C.; Perugini, M. Toxicological, Gene Expression and Histopathological Evaluations of Environmentally Realistic Concentrations of Polybrominated Diphenyl Ethers PBDE-47, PBDE-99 and PBDE-209 on Zebrafish Embryos. Ecotoxicol. Environ. Saf. 2019, 183, 109566. [Google Scholar] [CrossRef] [PubMed]
- Chen, G.; Konstantinov, A.D.; Chittim, B.G.; Joyce, E.M.; Bols, N.C.; Bunce, N.J. Synthesis of Polybrominated Diphenyl Ethers and Their Capacity to Induce CYP1A by the Ah Receptor Mediated Pathway. Environ. Sci. Technol. 2001, 35, 3749–3756. [Google Scholar] [CrossRef]
- Mai, B.; Chen, S.; Luo, X.; Chen, L.; Yang, Q.; Sheng, G.; Peng, P.; Fu, J.; Zeng, E. Distribution of Polybrominated Diphenyl Ethers in Sediments of the Pearl River Delta and Adjacent South China Sea. Environ. Sci. Technol. 2005, 39, 3521–3527. [Google Scholar] [CrossRef]
- Peng, W.; Lin, Y.; Wan, Z.; Ji, H.; Ma, W.; Zhao, J. An Unusual Dependency on the Hole-Scavengers in Photocatalytic Reductions Mediated by a Titanium-Based Metal-Organic Framework. Catal. Today 2020, 340, 86–91. [Google Scholar] [CrossRef]
- Qu, R.; Li, C.; Pan, X.; Zeng, X.; Liu, J.; Huang, Q.; Feng, J.; Wang, Z. Solid Surface-Mediated Photochemical Transformation of Decabromodiphenyl Ether (BDE-209) in Aqueous Solution. Water Res. 2017, 125, 114–122. [Google Scholar] [CrossRef]
- Yu, K.; Gu, C.; Boyd, S.A.; Liu, C.; Sun, C.; Teppen, B.J.; Li, H. Rapid and Extensive Debromination of Decabromodiphenyl Ether by Smectite Clay-Templated Subnanoscale Zero-Valent Iron. Environ. Sci. Technol. 2012, 46, 8969–8975. [Google Scholar] [CrossRef]
- Wei, X.; Yin, H.; Peng, H.; Chen, R.; Lu, G.; Dang, Z. Reductive Debromination of Decabromodiphenyl Ether by Iron Sulfide-Coated Nanoscale Zerovalent Iron: Mechanistic Insights from Fe(II) Dissolution and Solvent Kinetic Isotope Effects. Environ. Pollut. 2019, 253, 161–170. [Google Scholar] [CrossRef]
- Fu, R.; Mu, N.; Guo, X.; Xu, Z.; Bi, D. Removal of Decabromodiphenyl Ether (BDE-209) by Sepiolite-Supported Nanoscale Zerovalent Iron. Front. Environ. Sci. Eng. 2015, 9, 867–878. [Google Scholar] [CrossRef]
- Zhu, X.; Zhong, Y.; Wang, H.; Li, D.; Deng, Y.; Peng, P. New Insights into the Anaerobic Microbial Degradation of Decabrominated Diphenyl Ether (BDE-209) in Coastal Marine Sediments. Environ. Pollut. 2019, 255, 113151. [Google Scholar] [CrossRef] [PubMed]
- Yu, Y.; Yin, H.; Peng, H.; Lu, G.; Dang, Z. Proteomic Mechanism of Decabromodiphenyl Ether (BDE-209) Biodegradation by Microbacterium Y2 and Its Potential in Remediation of BDE-209 Contaminated Water-Sediment System. J. Hazard Mater. 2020, 387, 121708. [Google Scholar] [CrossRef] [PubMed]
- Wu, Z.; Xie, M.; Li, Y.; Gao, G.; Bartlam, M.; Wang, Y. Biodegradation of Decabromodiphenyl Ether (BDE 209) by a Newly Isolated Bacterium from an e-Waste Recycling Area. AMB Express 2018, 8, 27. [Google Scholar] [CrossRef] [PubMed]
- Liu, L.; Zhang, Y.; Liu, R.; Wang, Z.; Xu, F.; Chen, Y.; Lin, K. Aerobic Debromination of BDE-209 by Rhodococcus Sp. Coupled with Zerovalent Iron/Activated Carbon. Environ. Sci. Pollut. Res. Int. 2016, 23, 3925–3933. [Google Scholar] [CrossRef] [PubMed]
- Paliya, S.; Mandpe, A.; Kumar, M.S.; Kumar, S. Aerobic Degradation of Decabrominated Diphenyl Ether through a Novel Bacterium Isolated from Municipal Waste Dumping Site: Identification, Degradation and Metabolic Pathway. Bioresour. Technol. 2021, 333, 125208. [Google Scholar] [CrossRef]
- Tang, S.; Yin, H.; Chen, S.; Peng, H.; Chang, J.; Liu, Z.; Dang, Z. Aerobic Degradation of BDE-209 by Enterococcus Casseliflavus: Isolation, Identification and Cell Changes during Degradation Process. J. Hazard Mater. 2016, 308, 335–342. [Google Scholar] [CrossRef]
- Tang, S.; Bai, J.; Yin, H.; Ye, J.; Peng, H.; Liu, Z.; Dang, Z. Tea Saponin Enhanced Biodegradation of Decabromodiphenyl Ether by Brevibacillus Brevis. Chemosphere 2014, 114, 255–261. [Google Scholar] [CrossRef]
- Shi, G.; Yin, H.; Ye, J.; Peng, H.; Li, J.; Luo, C. Aerobic Biotransformation of Decabromodiphenyl Ether (PBDE-209) by Pseudomonas Aeruginosa. Chemosphere 2013, 93, 1487–1493. [Google Scholar] [CrossRef]
- Tang, C.; Fan, C.; Guo, D.; Ma, X.; Cai, Q.; Chen, X.; Zhang, M.; Li, J.; An, Q.; Zhao, R. Identification of Boseongicola Sediminum Sp. Nov., a Novel Decabromodiphenyl Ether (BDE-209)-Tolerant Strain Isolated from Coastal Sediment in Xiamen, China. Biomed. Environ. Sci. 2021, 34, 656–661. [Google Scholar] [CrossRef]
- Young, C.C. Bergey’s Manual of Determinative Bacteriology. J. Am. Pharm. Assoc. (Sci. Ed.) 1926, 47, 520. [Google Scholar] [CrossRef][Green Version]
- Kreig, N.R.; Holt, J.G.; Murray, R.G.E.; Breener, D.J.; Bryant, M.P.; Holt, J.G.; Moulder, J.W.; Pfennig, N.; Sneath, P.H.A.; Staley, J.T. Bergey’s Manual of Systematic Bacteriology. Volume 1. Bergeys Man. Syst. Bacteriol. 1989, 38, 89–100. [Google Scholar] [CrossRef]
- Li, M.; Gao, X.; Li, C.; Yang, C.; Fu, C.; Liu, J.; Wang, R.; Chen, L.; Lin, J.; Liu, X.; et al. Isolation and Identification of Chromium Reducing Bacillus Cereus Species from Chromium-Contaminated Soil for the Biological Detoxification of Chromium. Int. J. Environ. Res. Public Health 2020, 17, 2118. [Google Scholar] [CrossRef] [PubMed]
- Yang, Z.; Chen, J.; Qin, B.; Li, Y.; Zhang, Q.; Zhao, X.; Zhang, T. Characterization and Catabolic Genes Detection of Three Oil-Degrading Rhodococcus Spp. Chin. J. Appl. Environ. Biol. 2015, 21, 8. [Google Scholar] [CrossRef]
- Iwabuchi, N.; Sunairi, M.; Anzai, H.; Nakajima, M.; Harayama, S. Relationships between Colony Morphotypes and Oil Tolerance in Rhodococcus rhodochrous. Appl. Environ. Microbiol. 2000, 66, 5073–5077. [Google Scholar] [CrossRef]
- Zhao, H.; Tian, K.; Qiu, Q.; Wang, Y.; Zhang, H.; Ma, S.; Jin, S.; Huo, H. Genome Analysis of Rhodococcus Sp. DSSKP-R-001: A Highly Effective β-Estradiol-Degrading Bacterium. Int. J. Genom. 2018, 2018, 3505428. [Google Scholar] [CrossRef]
- Le, N.C.; Mikolasch, A.; Klenk, H.P.; Schauer, F. Degradation of the Multiple Branched Alkane 2,6,10,14-Tetramethyl-Pentadecane (Pristane) in Rhodococcus ruber and Mycobacterium neoaurum. Int. Biodeterior. Biodegrad. 2009, 63, 201–207. [Google Scholar] [CrossRef]
- Lee, E.H.; Kim, J.; Cho, K.-S.; Ahn, Y.G.; Hwang, G.S. Degradation of Hexane and Other Recalcitrant Hydrocarbons by a Novel Isolate, Rhodococcus Sp. EH831. Environ. Sci. Pollut. Res. Int. 2010, 17, 64–77. [Google Scholar] [CrossRef]
- Yam, K.C.; Geize, R.; Eltis, L.D. Catabolism of Aromatic Compounds and Steroids by Rhodococcus. In Biology of Rhodococcu; Springer: Berlin/Heidelberg, Germany, 2010. [Google Scholar] [CrossRef]
- Navarro-Llorens, J.M.; Patrauchan, M.A.; Stewart, G.R.; Davies, J.E.; Eltis, L.D.; Mohn, W.W. Phenylacetate Catabolism in Rhodococcus Sp. Strain RHA1: A Central Pathway for Degradation of Aromatic Compounds. J. Bacteriol. 2005, 187, 4497–4504. [Google Scholar] [CrossRef]
- Wang, L.; Tang, L.; Wang, R.; Wang, X.; Ye, J.; Long, Y. Biosorption and Degradation of Decabromodiphenyl Ether by Brevibacillus Brevis and the Influence of Decabromodiphenyl Ether on Cellular Metabolic Responses. Environ. Sci. Pollut. Res. Int. 2016, 23, 5166–5178. [Google Scholar] [CrossRef]
- Deng, D.; Guo, J.; Sun, G.; Chen, X.; Qiu, M.; Xu, M. Aerobic Debromination of Deca-BDE: Isolation and Characterization of an Indigenous Isolate from a PBDE Contaminated Sediment. Int. Biodeterior. Biodegrad. 2011, 65, 465–469. [Google Scholar] [CrossRef]
- Fang, T.; Zhou, N. Purification and Characterization of Salicylate 5-Hydroxylase, a Three-Component Monooxygenase from Ralstonia Sp. Strain U2. Appl. Microbiol. Biotechnol. 2014, 98, 671–679. [Google Scholar] [CrossRef] [PubMed]
- Grund, E.; Denecke, B.; Eichenlaub, R. Naphthalene Degradation via Salicylate and Gentisate by Rhodococcus Sp. Strain B4. Appl. Environ. Microbiol. 1992, 58, 1874–1877. [Google Scholar] [CrossRef] [PubMed]
- Bosch, R.; Moore, E.R.; García-Valdés, E.; Pieper, D.H. NahW, a Novel, Inducible Salicylate Hydroxylase Involved in Mineralization of Naphthalene by Pseudomonas Stutzeri AN10. J. Bacteriol. 1999, 181, 2315–2322. [Google Scholar] [CrossRef]
- Overwin, H.; González, M.; Méndez, V.; Seeger, M.; Wray, V.; Hofer, B. Dioxygenation of the Biphenyl Dioxygenation Product. Appl. Environ. Microbiol. 2012, 78, 4529–4532. [Google Scholar] [CrossRef]

| Characteristics | Results | Characteristics | Results |
|---|---|---|---|
| Physiology and Biochemistry | Arginine dihydrolase | − | |
| Gram stain | + | Qiyeling hydrolysis | + |
| Starch hydrolysis | − | D-maltose | + |
| V–P | − | Decanoic acid | − |
| Catalase | + | Adipic acid | + |
| Contact oxidase | − | Malic acid | + |
| API 20E | Citric acid | + | |
| Arginine | − | Phenylacetic acid | − |
| Dihydrolase | − | API ZYM | |
| Lysine decarboxylase | − | Alkaline phosphatase | + |
| Ornithine decarboxylase | + | Esterase (C4) | − |
| The generation of H2S | − | Lipoesterase (C8) | − |
| Urea enzyme | − | Lipase (C14) | W |
| Tryptophan deaminase | − | Leucine arylamidase | + |
| Indole production | − | Valine arylase | W |
| Production of acetylmethyl methanol | + | Cystine arylamidase | − |
| Gelatinase | − | Trypsin | W |
| Glucose fermentation | − | Acid phosphatase | W |
| Sucrose fermentation | − | Naphthol-AS-BI-phosphate hydrolase | − |
| API 20NE | − | α-galactosidase | − |
| Nitrate reduction (NO3-) | + | β-galactosidase | − |
| Nitrate reduction (NO2-) | + | α-glucosidase | + |
| Indole production | − | β-glucosidase | − |
| Glucose acidification | − | N-acetyl-β-glucosaminidase | − |
| Categories | Results | Categories | Results |
|---|---|---|---|
| Bases in all scaffolds | 5,395,558 bp | Contig N50 | 15,825 bp |
| G + C content | 70.44% | Gene num | 5046 |
| No. of large scaffolds (>1000 bp) | 440 | Gene total length | 4,603,239 bp |
| Scaffold N50 | 22,120 bp | tRNA | 55 |
| No. of large contigs (>1000 bp) | 562 | rRNA | 1 |
| Stain | Orf Number | Dehalogenase | Microorganism | Similarity |
|---|---|---|---|---|
| TAW-CT127 | orf02266 | Aloalkane dehalogenase | Rhodococcus sp. P14 | 100% |
| TAW-CT127 | orf02896 | Haloacid dehalogenase | Rhodococcus | 100% |
| TAW-CT127 | orf02614 | Haloacid dehalogenase | Rhodococcus | 100% |
| TAW-CT127 | orf02255 | Haloacid dehalogenase | Rhodococcus ruber | 100% |
| TAW-CT127 | orf03435 | Haloacid dehalogenase | Rhodococcus sp. P14 | 100% |
| TAW-CT127 | orf04248 | Haloacid dehalogenase | Rhodococcus sp. P14 | 100% |
| TAW-CT127 | orf01345 | Haloacid dehalogenase | Rhodococcus | 100% |
| TAW-CT127 | orf04277 | Haloacid dehalogenase | Rhodococcus ruber | 100% |
| TAW-CT127 | orf02806 | Haloacid dehalogenase | Rhodococcus ruber | 98% |
| TAW-CT127 | orf00660 | Haloacid dehalogenase | Rhodococcus | 100% |
| Stain | Orf Number | Description | Microorganism | Similarity |
|---|---|---|---|---|
| TAW-CT127 | orf00636 | Biphenyl-2,3-dioxygenase | Rhodococcus ruber | 100% |
| TAW-CT127 | orf03939 | Biphenyl-2,3-dioxygenase | Rhodococcus | 100% |
Publisher’s Note: MDPI stays neutral with regard to jurisdictional claims in published maps and institutional affiliations. |
© 2022 by the authors. Licensee MDPI, Basel, Switzerland. This article is an open access article distributed under the terms and conditions of the Creative Commons Attribution (CC BY) license (https://creativecommons.org/licenses/by/4.0/).
Share and Cite
Xu, H.; Cai, Q.; An, Q.; Tang, C.; Wang, W.; Wang, G.; You, W.; Guo, D.; Zhao, R. Aerobic Degradation Characteristics of Decabromodiphenyl ether through Rhodococcus ruber TAW-CT127 and Its Preliminary Genome Analysis. Microorganisms 2022, 10, 1441. https://doi.org/10.3390/microorganisms10071441
Xu H, Cai Q, An Q, Tang C, Wang W, Wang G, You W, Guo D, Zhao R. Aerobic Degradation Characteristics of Decabromodiphenyl ether through Rhodococcus ruber TAW-CT127 and Its Preliminary Genome Analysis. Microorganisms. 2022; 10(7):1441. https://doi.org/10.3390/microorganisms10071441
Chicago/Turabian StyleXu, Hao, Qingtao Cai, Qiuying An, Chen Tang, Wanpeng Wang, Guangshun Wang, Wanting You, Dongbei Guo, and Ran Zhao. 2022. "Aerobic Degradation Characteristics of Decabromodiphenyl ether through Rhodococcus ruber TAW-CT127 and Its Preliminary Genome Analysis" Microorganisms 10, no. 7: 1441. https://doi.org/10.3390/microorganisms10071441
APA StyleXu, H., Cai, Q., An, Q., Tang, C., Wang, W., Wang, G., You, W., Guo, D., & Zhao, R. (2022). Aerobic Degradation Characteristics of Decabromodiphenyl ether through Rhodococcus ruber TAW-CT127 and Its Preliminary Genome Analysis. Microorganisms, 10(7), 1441. https://doi.org/10.3390/microorganisms10071441

